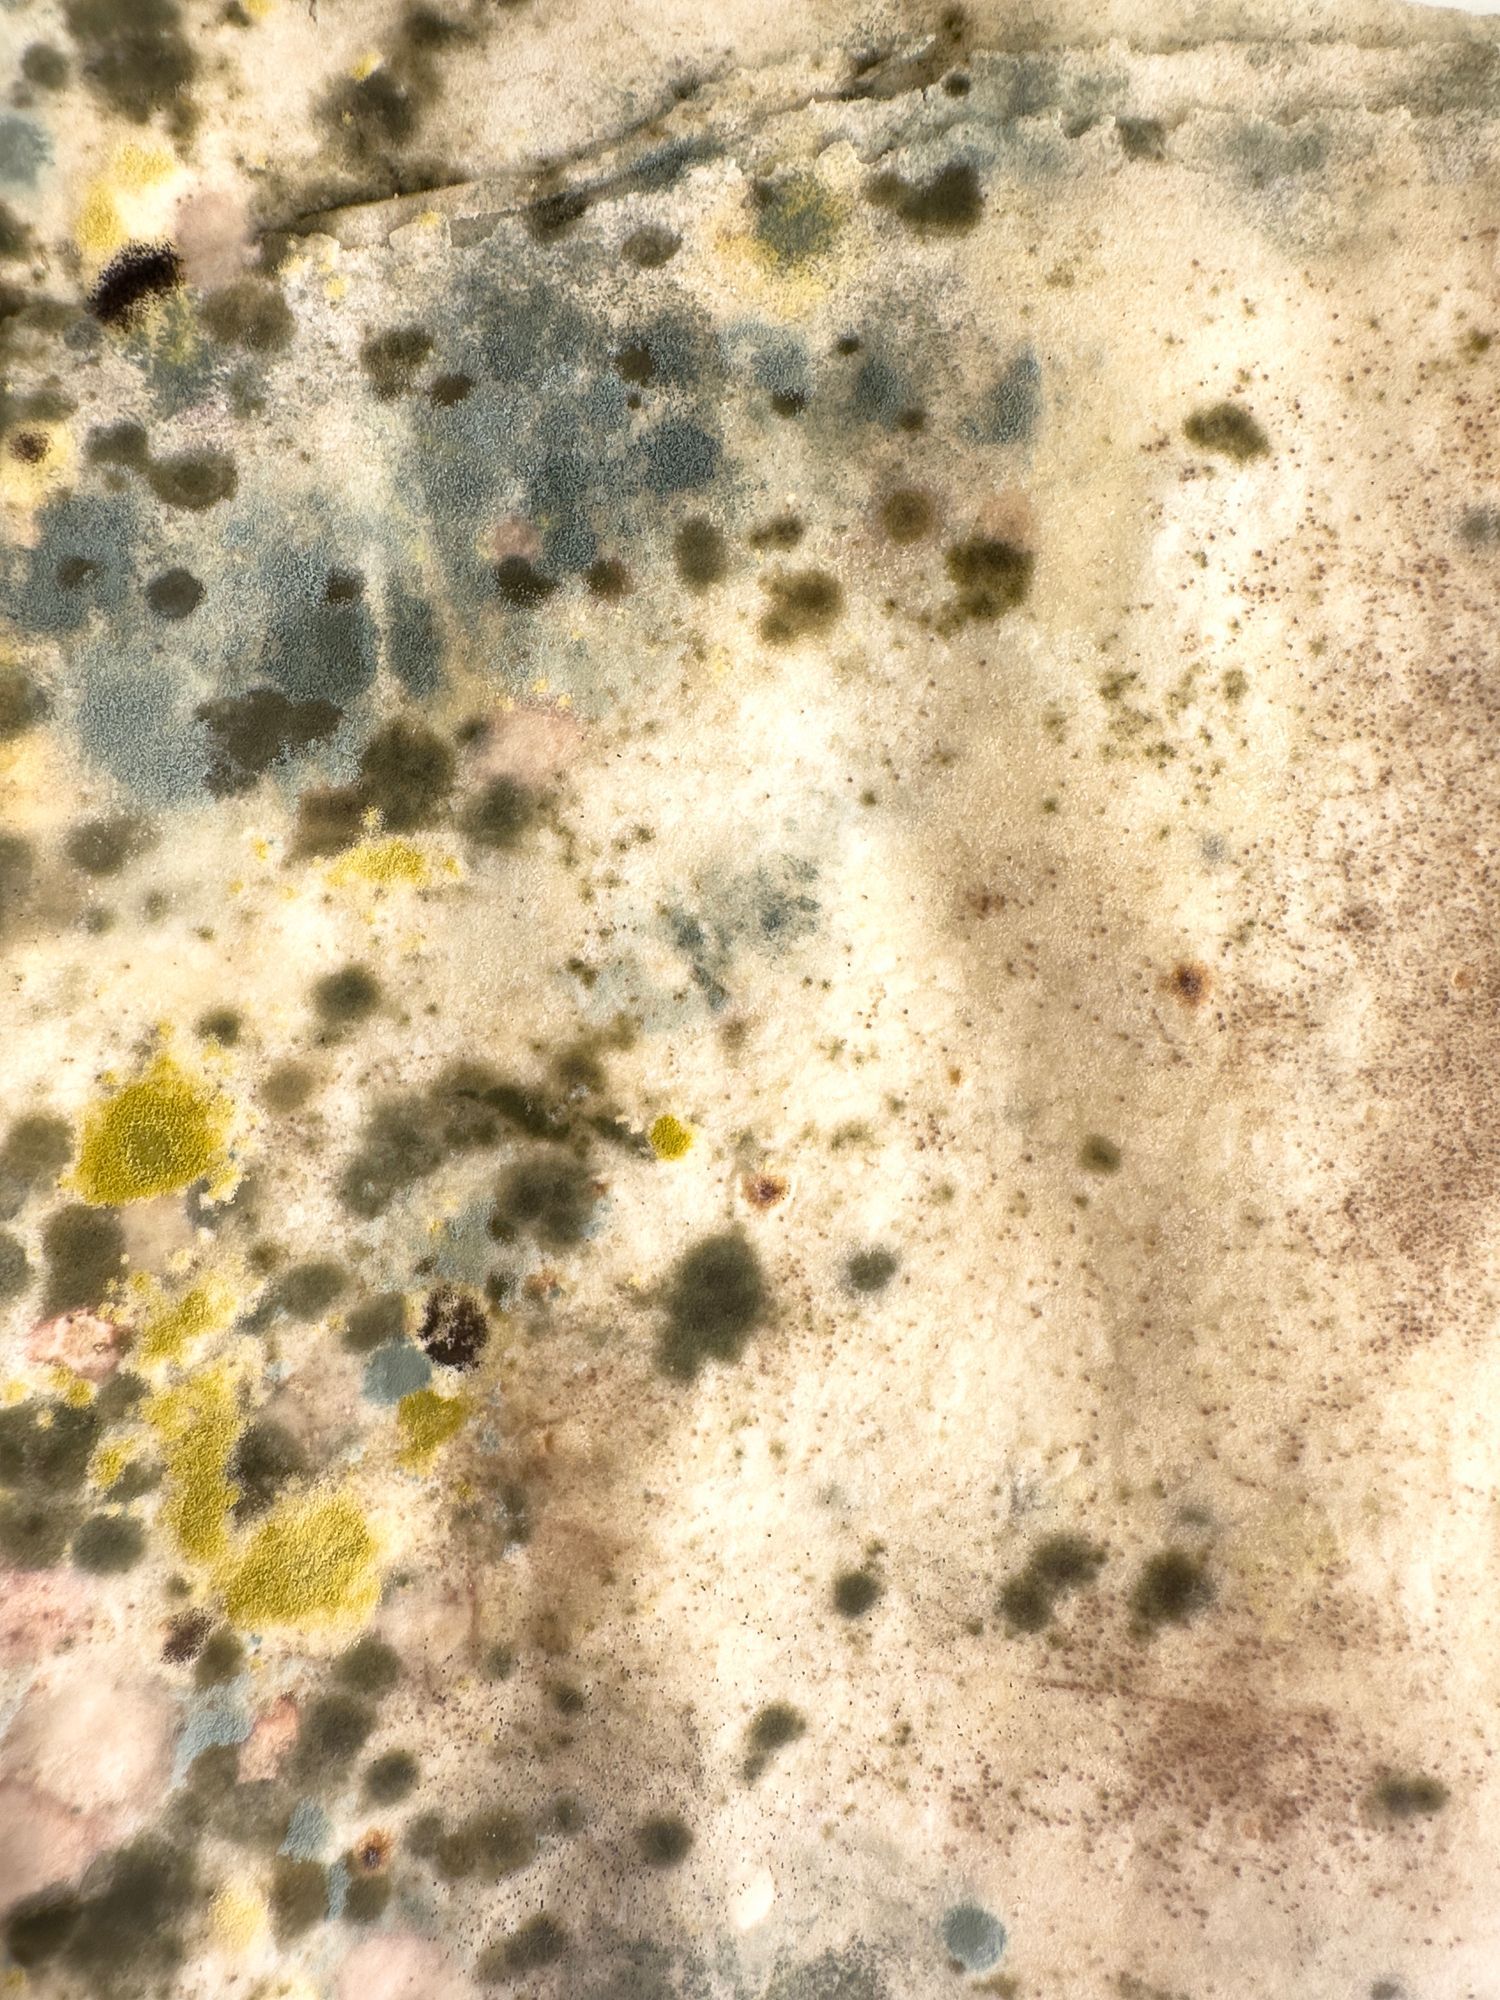
A man is laying on a white sheet in a basement.

Reliable Home Inspections Across Central North Carolina
Meet Sean
I am a New England native who moved here to Sanford with my wife several years ago and has been blessed to call this our home. Some of my passions are playing pickleball, spending time with friends, and fostering cats/kittens after adopting two kittens in recent years. Having experienced the home buying/building process a few years ago, becoming a home inspector was a natural choice. Buying a home should be a positive experience, and I am dedicated to ensuring that my clients have the information they need to make an informed decision.
As a home inspector, I have the privilege of playing a small but significant role in one of the most important purchases of a person’s life. Therefore, I take this responsibility seriously and approach each inspection with the same care and attention to detail.
I thoroughly inspect every aspect of a property, from the roof to the ground, and provide a comprehensive report highlighting any issues or concerns. My goal is to give my clients peace of mind, knowing that they completely understand the condition of the home they are considering purchasing. I look forward to continuing to serve my clients with integrity, professionalism, and a commitment to excellence.
Inspection Services
A THOROUGH HOME INSPECTION COULD SAVE YOU THOUSANDS OF DOLLARS!
Home Inspection
A thorough examination of a property’s condition, where we will inspect, test, probe, and/or evaluate many of the home’s components from the roof to the ground.
HVAC Inspection
We partner with Carolina Heating & Air to inspect and evaluate the HVAC system to ensure proper performance. This will include Freon levels, valves, capacitors, and/or other components of the system. Pictures will be provided and quotes if necessary.
Mold & Particle ID Testing
We test for many types of mold and/or 40+ types of airborne particle debris to ensure your home is safe for you and your loved ones.
Manufactured Home Certifications
Ensure your manufactured home meets all standards. Our expert detailed reports partnering with MFD Home Certs will provide you with all of the information you need to verify your home may need today's HUD standards.
Commercial Inspections
We deliver expert commercial property inspections while holding a Master Commercial Inspector LVL III Certification. Ensure your property is safe, functional, and in accordance with today’s standards with our thorough assessments.
New Construction
A final phase construction inspection is a thorough assessment by a licensed home inspector conducted just before a newly built home is completed and turned over to the buyer. It typically happens after all major construction is done—think framing, plumbing, electrical, HVAC, and finishes like drywall and flooring—but before the final walkthrough with the builder.
I will look at structural integrity, safety features (like smoke detectors), and functionality of systems, spotting defects or incomplete work—like leaky pipes, faulty wiring, or poor insulation—that could cause issues later. It’s the buyer’s chance to catch problems early, ensuring the builder fixes them before move-in, rather than dealing with headaches (or costs) down the line.
Pest Service
We partner with Canady’s Pest Services to inspect for
termites, pests, and signs of damage while being able to provide quotes for your peace of mind.
Pre-Drywall
The property is inspected to ensure that plumbing lines, electrical components, and HVAC components are placed and secured properly while also inspecting for structural concerns and any exterior issues. By doing this, we ensure that all visible areas of the framing have been inspected, which can reduce or eliminate potential areas of concern that typically are found during the final phase process.
Pre-Listing Inspections
A pre-listing inspection is a professional evaluation of a home’s condition conducted by a licensed home inspector before the property is put on the market for sale regarding anything that could affect the home’s value or appeal to buyers. By knowing the home’s condition upfront, sellers can decide whether to fix problems before listing, adjust the asking price to reflect the issues, or disclose them to potential buyers to build trust and streamline the sale process.
Radon Testing
Radon testing is the process of measuring the levels of radon, a naturally occurring radioactive gas, in a home. Radon comes from the breakdown of uranium in soil and rock beneath buildings and can seep into homes through cracks in foundations, gaps, or water supplies. It’s odorless, colorless, and tasteless, so testing is the only way to detect it. Prolonged exposure to high levels can increase the risk of lung cancer—it’s actually the second-leading cause after smoking. The EPA recommends testing every home since radon can be an issue anywhere, not just in specific regions. It’s about peace of mind and keeping the air safe to breathe.
Roof Inspections
We will walk the roof when safe and practical or utilize aerial imagery when necessary to examine all areas of the exterior roof structure.
Verification of Repairs
We verify that repairs comply with standards and codes—our report details repair quality and completeness.
Water Testing
Well water testing checks the quality and safety of water from private wells, since they aren’t regulated like public water systems. Options include
Microbiological Test: Look for bacteria (like coliform or E. coli).
Full Panel Tests: microbiological and also lead, nitrates, and nitrides
Schedule your inspection
10% discount for military, medical, educational, and social services.